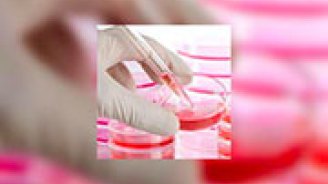

Sommaire
Don de sang de cordon : à quoi ça sert ?
Bébé est bientôt là ? Votre gynécologue vous a peut-être déjà proposé de faire don du sang de cordon de votre bambin après la naissance. À quoi cela sert-il ? Le don de sang de cordon est-il dangereux ou douloureux ? Pouvez-vous refuser ?Quelques éléments de réponse pour prendre votre décision en toute quiétude.
Sang du cordon : une source de cellules souches
Comme la moelle osseuse, le sang du cordon de votre enfant est riche en cellules souches hématopoïétiques, qui peuvent donner naissance à n'importe quelle autre cellule du sang : globules rouges, globules blancs, plaquettes...
Ces précieuses cellules permettent donc de lutter contre certaines maladies hématologiques, comme les leucémies ou les lymphomes. Il faut pour cela les greffer à la personne malade afin de « renouveler » son sang, et de la guérir.
Certes, il est possible de faire des dons de moelle osseuse pour lutter contre ces mêmes maladies, mais c'est une procédure compliquée et douloureuse pour le donneur.
En comparaison, le sang du cordon est très facile à prélever. En plus les cellules qu'il contient sont mieux tolérées lors de la greffe.
Des examens complémentaires en vue du don de sang de cordon
Vous êtes partante pour un don de sang de cordon ?
Après avoir vérifié vos antécédents et qu'aucune contre-indication n'existe - vous ne souffrez d'aucune maladie génétique par exemple -, votre médecin vous fait signer un formulaire de consentement. Il effectue une prise de sang afin de réaliser quelques examens complémentaires, pour s'assurer par exemple que vous ne souffrez pas d'une infection. Un deuxième formulaire de consentement peut également être signé si vous acceptez que ce don soit également utilisé pour la recherche.
Et si vous hésitez ?
Vous pouvez tout à fait refuser, cela n'aura aucun impact sur votre suivi. Si vous acceptez, il reste possible de vous rétracter jusqu'à 6 mois après la naissance au cas où vous changeriez d'avis.
$$Le don de sang de cordon en pratique
Thomas Coucq, journaliste santé
Maladies graves et redoutées : définition, ALD et enjeux en prévoyance
Découvrez ce que recouvrent les maladies graves et redoutées, leur lien avec les affections de longue durée (ALD) et leur impact sur l’assurance emprunteur, santé ou prévoyance, à la lumière de la loi Lemoine et de la convention AERAS.
7 min